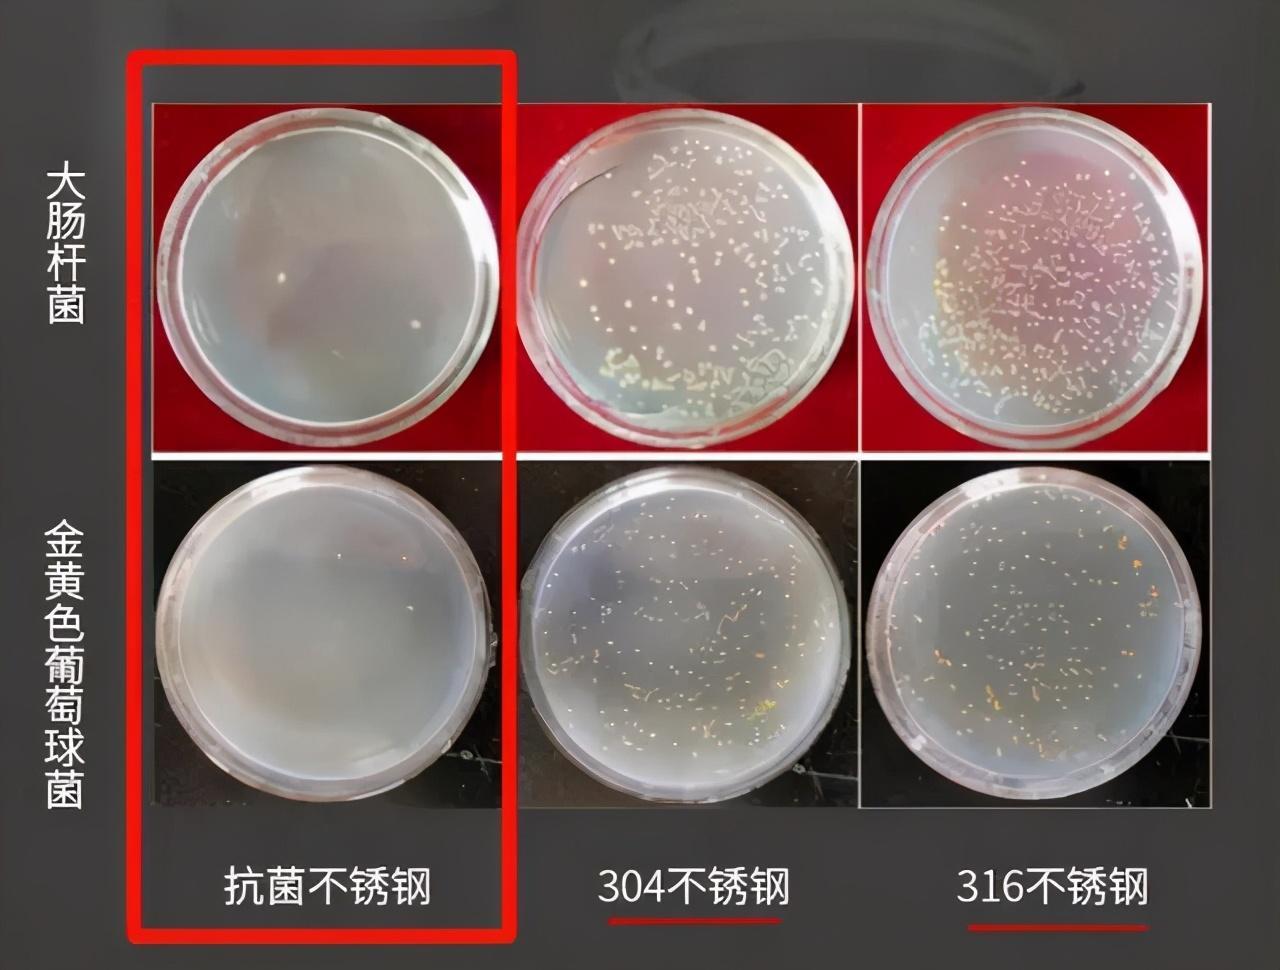

中科院这项发明,或将改变316不锈钢的地位,已经用在餐具上了
中科院这项发明,或将改变316不锈钢的地位,已经用在餐具上了
在生活中,很多人应该都是有用过不锈钢产品的,比如:不锈钢碗、筷子、保温杯、烧水壶等,或者说不锈钢产品已经成了我们生活的一部分了。

不是任何的一种不锈钢都能来做饮食工具,必须要达到食品级别的,我们常用的不锈钢一般都是304不锈钢,这个价格相对较低,也满足食品安全要求,只要是正规合规的产品,上面都会有“SUS 304”标识。

另外一种是316不锈钢,因其添加了钼(化学元素Mo),其物理化学性能比304更好,在生活中也能看到316不锈钢的餐具,但价格就要比304贵很多,主要应用在生产有腐蚀性产品的设备、食品工业等。

316和304不具有抗菌效果,如果不锈钢本身能抗菌,这对健康来说无疑是一种很大的突破。

中科院金属研究所就用了5年时间来研究抗菌不锈钢,终于研究成功了,经过实验测试,其抗菌效果达到了99%,突破了316和304不锈钢的限制。
并且还具有广谱性和持久性,也就是说不止针对一种细菌有效,对多种细菌都有作用,而这种抗菌作用至少10年都是有效果的。

数据来自中国科学院金属研究所官网
跟316和304的最大区别,就是有着99%的抗菌,其物理和化学性能也保持了不锈钢的特性。316不锈钢的地位,或将被中科院这项发明改变。
对比抗菌效果
这一发明,在当时获得了很高的评价,被认为填补了国内不锈钢材料的空白,也获得了国家发明专利,央视也对抗菌不锈钢材料做个报道。

Geego这个品牌是专门做不锈钢餐具的,为了跟进这种抗菌不锈钢材质,经过了很多努力,现在已经能够很成熟地生产抗菌不锈钢产品了,且获得了用户广泛地认可。
抗菌不锈钢筷子
吃饭的时候,筷子要经常给我们的嘴接触,而传统的竹木筷子很容易发霉,对我们的健康有很大的隐患,特别是对小孩子和老年人。

为了健康,很多人的使用习惯也在不断改变,改用不锈钢筷子,在这之前市面上的基本上都是304/316不锈钢的,99%抗菌不锈钢的应用,提高了健康安全系数。

Geego这双筷子处理有很好的抗菌效果,还具有很好的防滑、防烫设计。
筷子的头部用了激光菱形雕刻技术,筷尾采用了激光雕刻+磨砂工艺,不仅夹菜不容易滑,手拿着筷子也更稳,用起来更顺手。

中空防烫设计,能够尽可能地降低筷子的温度,拿在手上也不会觉得烫,同时还能减轻筷子的重量,拿着不那么累。

点击下方链接即可购买抗菌筷子!
Geego 抗菌不锈钢筷子10双装
¥49
购买
抗菌不锈钢菜板
菜板这一块也是容易忽略的重灾区,传统的菜板很容易发霉,容易掉木屑、残留食物残渣等,据相关测试数据显示,菜板上的细菌比马桶盖还多。而且生熟食共用一块菜板,很容易吃坏肚子。

大家对不锈钢菜板的第一反应可能就是,这能用吗?费刀吗?
用过Geego的这个不锈钢菜板之后,发现这些担心是多余的,可以用而且不费刀,也没有刺耳的声音。
抗菌不锈钢的硬度比刀口的硬度要小一些,用了一个月之后刀口没有变钝,唯一有点不足的是,菜板上会有印子,不过这个不会像木菜板一样掉屑的,可以放心地使用。

因为有99%抗菌效果,非常适合切一些肉类、海鲜等食物,能够起到保鲜的作用。
菜板还是两面设计,一面是不锈钢材质,另一面是食品级PP材质,一板两用,可以生熟食物分开切,还能斩骨头,更加健康方便。

还有一个很细节的设计,菜板两面都做了防溢水槽设计,我们在切食物的时候,不用担心水流到案板了,用后只需冲洗下菜板,同时保持了案板的卫生。

点击下方链接即可购买抗菌菜板!
Geego抗菌不锈钢砧板
¥89
购买
抗菌不锈钢碗
越来越多的家庭都开始使用不锈钢碗了,轻巧、耐摔,比陶瓷碗更耐用,家里如果有小孩的,几乎是必备的。

Geego不锈钢碗不仅有99%抗菌效果,还具有很到隔热和保温作用。
采用了双层加厚中空隔热设计,可以有效地防止烫手,把刚烧开的100℃的水倒里面,也不会觉得很烫手,可以一直端在手里。这种设计还有一个好处,能够起到一定的保温效果,孩子吃饭时间比较长,这样可以让饭菜冷得不那么快。

在工艺上采用了外部拉丝工艺+内部镜面抛光工艺,看上去很具有品质和质感。

点击下方链接可购买抗菌碗,也有儿童碗哦!
Geego抗菌不锈钢碗
¥39
购买
抗菌饭盒
在公司上班,“中午吃什么”成了很多上班族的难题。外卖吃腻、出去吃麻烦,很多上班族都会选择自己带午餐,这样节约、省事又健康。

带午餐就要选择一个好的饭盒,尽可能地保留饭菜的原来的口味。
Geego这款抗菌不锈钢饭盒,利用抗菌的功能,跟普通饭盒相比具有一定的保鲜作用。

而且,饭盒采用了分格设计,总共有4个小格,可以很好地把不同的菜和饭分开,避免串味,带饭终于可以不用吃盖浇饭了。

还有一点不一样的是,饭盒能够保温,当我们在饭盒的底层加入开水,可以保温到中午,下班的时候直接打开就能吃,也不用排队去用微波炉加热了,更加的方便。

盖子还可以秒变手机支架,中午吃饭的时候想放松下心情,把手机放在盖子上看会视频,也是一个很不错的选择。

点击下方链接,即可购买抗菌饭盒(送抗菌筷勺)!
Geego抗菌分格便携大容量饭盒
¥79
购买
中科院抗菌不锈钢在餐具上的使用,给我们的健康又加了一道安全防线,
-

- 动漫人物分析:兽之巨人吉克·耶格尔-一名影帝的自我修养
-
2026-03-15 06:06:08
-

- 投资中最简单的事
-
2026-03-15 06:03:54
-

- 90后女孩开18米大货车,跑遍全国,霸气征婚:月入2万,我养你
-
2026-03-15 00:29:25
-

- 将军的血脉:现代德川一族,从东京诅咒到政坛角逐
-
2026-03-15 00:27:11
-

- 建筑工程“图纸代号符号”表示大全,看懂图就靠它!设计图纸大全
-
2026-03-15 00:24:56
-

- 十部豆瓣评分最高的电视剧分享,快来看看你看哪些?
-
2026-03-15 00:22:42
-

- 一文读懂清末民初的军阀割据
-
2026-03-15 00:20:28
-

- 3本系统文,系统在手,天下我有,好看的无限流小说你值得拥有!
-
2026-03-15 00:18:13
-

- 《千字文》详解之二:天地玄黄,宇宙洪荒
-
2026-03-15 00:15:59
-

- 聚美陈欧:3年败光120亿,3亿买项目被王思聪吐槽,如今怎么样了
-
2026-03-15 00:13:45
-

- 志愿军的冲锋号为何被称为魔笛,军号战术击溃敌军
-
2026-03-15 00:11:30
-

- 秦海璐14年“豪迈感情史”,如今被王新军宠成公主!她确实值得
-
2026-03-15 00:09:16
-

- 钢铁侠十套最强大的战甲,有钱真的可以为所欲为?
-
2026-03-14 18:18:59
-

- 核武器的前世今生,你了解吗?
-
2026-03-14 18:16:45
-

- 山西省应该向优秀的陕西省好好学习经验
-
2026-03-14 18:14:30
-

- 最新高清版:从卫星地图看惠州7个县区的建成区规模
-
2026-03-14 18:12:16
-

- 11岁儿子要摸着妈妈胸入睡,妈妈一脸享受,网友表示毁三观
-
2026-03-14 18:10:02
-

- 病入膏肓,你会选安乐死吗?
-
2026-03-14 18:07:47
-

- 曹彰:三国时期的猛将
-
2026-03-14 18:05:33
-

- 曾拿南京大屠杀等民族惨痛记忆作调侃,斗鱼主播陈一发被网警点名
-
2026-03-14 18:03:19



 姜昆、侯耀华、石富宽、王谦祥见到马志明怎么称呼?
姜昆、侯耀华、石富宽、王谦祥见到马志明怎么称呼? 这些令人胆颤心惊的动漫痴女,如果出现在三次元中,你吃得消么?
这些令人胆颤心惊的动漫痴女,如果出现在三次元中,你吃得消么?